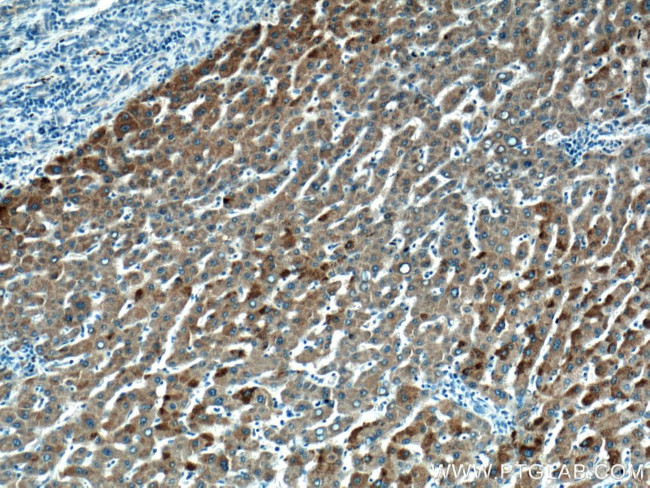
HMGCLL1 Antibody in Immunohistochemistry (Paraffin) (IHC (P))

Search
Proteintech
HMGCLL1 Polyclonal Antibody
{{$productOrderCtrl.translations['antibody.pdp.commerceCard.promotion.promotions']}}
{{$productOrderCtrl.translations['antibody.pdp.commerceCard.promotion.viewpromo']}}
{{$productOrderCtrl.translations['antibody.pdp.commerceCard.promotion.promocode']}}: {{promo.promoCode}} {{promo.promoTitle}} {{promo.promoDescription}}. {{$productOrderCtrl.translations['antibody.pdp.commerceCard.promotion.learnmore']}}
产品信息
17206-1-AP
种属反应
宿主/亚型
分类
类型
抗原
偶联物
形式
浓度
规格
纯化类型
保存液
内含物
保存条件
运输条件
产品详细信息
Immunogen sequence: MGNVPSAVK HCLSYQQLLR EHLWIGDSVA GALDPAQETS QLSGLPEFVK IVEVGPRDGL QNEKVIVPTD IKIEFINRLS QTGLSVIEVT SFVSSRWVPQ MADHTEVMKG IHQYPGVRYP VLTPNLQGFH HAVAAGATEI SVFGAASESF SKKNINCSIE ESMGKFEEVV KSARHMNIPA RGYVSCALGC PYEGSITPQK VTEVSKRLYG MGCYEISLGD TIGVGTPGSM KRMLESVMKE IPPGALAVHC HDTYGQALAN ILTALQMGIN VVDSAVSGLG GCPYAKGASG NVATEDLIYM LNGLGLNTGV NLYKVMEAGD FICKAVNKTT NSKVAQASFN A (1-340 aa encoded by BC024194)
靶标信息
HMGCLL1 gene ontology annotations related to this gene include ketone body biosynthetic process; leucine catabolic process; lipid metabolic process.
仅用于科研。不用于诊断过程。未经明确授权不得转售。
篇参考文献 (0)
生物信息学
蛋白别名: 3-hydroxy-3-methylglutaryl-CoA lyase, cytoplasmic; 3-hydroxy-3-methylglutaryl-CoA lyase-like protein 1; 3-hydroxymethyl-3-methylglutaryl-CoA lyase L1; 3-hydroxymethyl-3-methylglutaryl-CoA lyase like 1; 3-hydroxymethyl-3-methylglutaryl-CoA lyase-like protein 1; 3-hydroxymethyl-3-methylglutaryl-Coenzyme A lyase-like 1; Endoplasmic reticulum 3-hydroxy-3-methylglutaryl-CoA lyase; endoplasmic reticulum 3-hydroxymethyl-3-methylglutaryl-CoA lyase; endoplasmic reticulum and cytosol HMG-CoA lyase; er-cHL; HMGCL-like 1; probable 3-hydroxymethyl-3-methylglutaryl-CoA lyase 2; unnamed protein product
基因别名: bA418P12.1; er-cHL; ERCHL; HMGCLL1
UniProt ID: (Human) Q8TB92
Entrez Gene ID: (Human) 54511